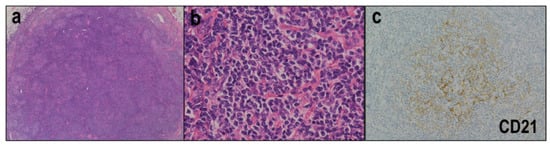

Abstract
Peripheral T-cell lymphomas (PTCLs) are uncommon neoplasms derived from mature T cells or NK cells. PTCLs comprise numerous disease entities, with over 30 distinct entities listed in the latest WHO classification. They predominantly affect adults and elderly people and usually exhibit an aggressive clinical course with poor prognosis. According to their presentation, PTCLs can be divided into nodal, extranodal or cutaneous, and leukemic types. The most frequent primary sites of PTCLs are lymph nodes, with over half of cases showing nodal presentation. Nodal PTCLs include ALK-positive and ALK-negative anaplastic large cell lymphoma; nodal T-cell lymphoma with T follicular helper cell origin; and PTCL, not otherwise specified. Adult T-cell leukemia/lymphoma also frequently affects lymph nodes. Recent pathological and molecular findings in nodal PTCLs have profoundly advanced the identification of tumor signatures and the refinement of the classification. Therefore, the therapies and pathological diagnosis of nodal PTCLs are continually evolving. This paper aims to provide a summary and update of the pathological and molecular features of nodal PTCLs, which will be helpful for diagnostic practice.
1. Introduction
Peripheral T-cell lymphomas (PTCLs) are uncommon neoplasms derived from mature T cells or NK cells. PTCLs collectively account for 10–15% of all non-Hodgkin lymphomas and usually exhibit an aggressive clinical course with poor prognosis [1,2,3]. They predominantly affect adults and elderly people and are more common in Asian than in Western countries.
PTCLs comprise numerous disease entities, with over 30 distinct entities of T-cell or NK-cell origin listed in the latest World Health Organization (WHO) classification of Tumors of Haematopoietic and Lymphoid Tissues [1]. In addition to histological and immunohistochemical signatures, recent molecular studies have profoundly contributed to the identification of tumor signatures and the refinement of the classification. According to their presentation, PTCLs can be divided into nodal, extranodal or cutaneous, and leukemic types [1,4]. The biological features of PTCLs are somewhat associated with the site of primary presentation. The most frequent primary sites of PTCLs are lymph nodes, with over half of cases showing nodal presentation.
In the current review, we summarize the pathological and molecular features of PTCLs that mainly or frequently show nodal presentation. Nodal PTCLs include ALK-positive (ALK+) and ALK-negative (ALK−) anaplastic large cell lymphoma (ALCL); nodal T-cell lymphoma with T follicular helper (TFH) cell origin; and PTCL, not otherwise specified (PTCL-NOS). Adult T-cell leukemia/lymphoma (ATLL) also frequently affects lymph nodes.
2. ALCL
According to the WHO classification, ALCLs are classified into four entities based on their clinical presentation and ALK expression. All four entities share the pathological features of strong and diffuse CD30 expression and the presence of characteristic cells called “hallmark cells” [1]. Systemic ALCL includes ALK+ ALCL and ALK− ALCL, while localized ALCL includes primary cutaneous (pc) ALCL and breast implant-associated (BIA) ALCL. ALK+ ALCL expresses the ALK protein due to chromosomal translocations involving the ALK gene. ALK− ALCL is systemic ALCL without ALK expression. pcALCL is a skin-limited disease and a pcCD30+ T-cell lymphoproliferative disorder. About 10% of patients with pcALCL exhibit extracutaneous lesions that mainly affect the regional lymph nodes [5,6]. BIA ALCL is a new entity that is now included as a provisional entity in the WHO classification. This disease arises in association with a breast implant and is usually limited to a seroma cavity around the implant and pericapsular fibrous tissue [7]. Among these four entities, ALK+ and ALK− ALCL frequently appear as nodal lesions at primary presentation. Next, we further describe ALK+ and ALK− ALCL.
2.1. ALK+ ALCL
2.1.1. Clinical Features
ALK+ ALCL mainly occurs in children and young adults and shows a male-to-female ratio of 3:2. Patients frequently have B-symptoms, especially high fever, and present with stage III-IV disease. Most patients present with nodal lesions, although extranodal involvement is often observed (60%). Overall, ALK+ ALCL has a better prognosis than ALK− ALCL, with a long-term overall survival of 80% [8,9].
2.1.2. Morphological and Immunohistochemical Features
ALK+ ALCLs are characterized by a broad spectrum of morphological and cytological features. However, all cases include a variable proportion of hallmark cells, which are large-sized cells with eccentric kidney- or horseshoe-shaped nuclei. They often have a paranuclear eosinophilic region [8,10]. According to the WHO classification, ALK+ ALCLs include five morphological patterns: common (60%), lymphohistiocytic (10%), small-cell (5–10%), Hodgkin-like (3%), and composite (15%) patterns [1].
The common pattern shows a sheet-like and cohesive growth pattern of large tumor cells with irregular nuclei, which may resemble Hodgkin–Reed–Sternberg cells. Some of them have hallmark cell features (Figure 1a), and the large neoplastic cells have rich cytoplasm with clear, basophilic, or eosinophilic features. Tumor cell sinusoidal involvement is often observed in lymph node lesions, which may mimic a metastatic malignant tumor.

Figure 1.
ALK-positive anaplastic large cell lymphoma (ALCL). (a) The common pattern shows a sheet-like and cohesive growth pattern of large tumor cells with irregular nuclei, some of which have hallmark cell features (HE × 400). (b) In the lymphohistiocytic pattern, neoplastic cells are scattered and admixed with abundant reactive histiocytes and small lymphocytes (HE × 400). (c) The common pattern shows diffuse and strong CD30 expression (×200). (d) In all ALK+ ALCL cases, the tumor cells express ALK (×200). (e) The lymphohistiocytic and small-cell patterns may show heterogenous CD30 expression patterns (×200). (f) ALK immunohistochemistry highlights the tumor cells of morphologic variants, which may contain scarce hallmark cells.
In the lymphohistiocytic pattern, neoplastic cells are scattered and admixed with abundant reactive histiocytes and small lymphocytes (Figure 1b) [11,12]. These reactive components may mask the tumor cells, leading to a misdiagnosis of a reactive lesion. Compared to the common pattern, this variant usually includes smaller tumor cells that often cluster around blood vessels. The small cell pattern includes numerous small-to-medium-sized tumor cells with irregular nuclei, pale cytoplasm, and a distinct membrane borderline. There are few hallmark cells, which tend to cluster around blood vessels [13]. These lymphohistiocytic and small cell patterns are closely related and often admixed [11,14]. Among the ALK+ ALCLs, these two morphological variants are associated with an unfavorable prognosis and leukemic presentation [11].
The Hodgkin-like pattern histologically resembles nodular sclerosis Hodgkin lymphoma [15]. Other rare patterns include cases with tumor cells showing giant-cell, sarcomatoid, or spindle-cell features [16,17]. The composite pattern includes the presence of two or more patterns in one lymph node.
Immunohistochemically, in all ALK+ ALCLs, the tumor cells are positive for CD30 on the cell membrane and the Golgi region (Figure 1c) and express ALK (Figure 1d). Large tumor cells show strong CD30 expression, while smaller tumor cells may show only weak or no CD30 expression. Therefore, the common pattern, which predominantly comprises large tumor cells, exhibits diffuse and strong CD30 expression (Figure 1c). In contrast, the lymphohistiocytic and small cell patterns may exhibit heterogenous CD30 expression (Figure 1e). As CD30 and ALK are definitional markers for ALK+ ALCL diagnosis, their evaluation is useful for accurate diagnosis, particularly to highlight the tumor cells of morphologic variants, in which hallmark cells may be scarce or masked by abundant inflammatory infiltrates (Figure 1f). Most cases are positive for EMA. Although most ALK+ ALCLs show a monoclonal rearrangement of the TCR genes, the tumor cells often lack T-cell antigen expression [18]. The majority of cases are negative for CD3, and many are also negative for CD5 and CD7. CD2 and CD4 are more useful and are positive in a substantial proportion of cases. Some cases may have an apparent null-cell immunophenotype. Most cases, even of the null-cell type, express cytotoxic markers, such as TIA-1, granzyme B, and/or perforin. CD8 is usually negative. By definition, ALCLs are negative for EBV.
2.1.3. Molecular Features
Chromosomal translocations involving the ALK gene on 2p23 lead to the expression of an ALK fusion protein. Approximately 80% of ALK+ ALCLs harbor t(2;5)(p23;q35), which results in the fusion of ALK and NPM1, and less common mutations include t(1;2)(q25;p23)/TPM3-ALK, inv(2)(p23q35)/ATIC-ALK, and other rare variants [1,19]. The ALK staining pattern differs according to the variant of translocation (Table 1). The aberrant expression of ALK fusion proteins leads to constitutive ALK tyrosine kinase activity and downstream activation of the JAK-STAT3 pathway [20].

Table 1.
Translocations and ALK staining pattern of ALK+ ALCL.
2.2. ALK− ALCL
2.2.1. DUSP22-Rearranged, TP63-Rearranged, and Triple-Negative ALCL
All systemic ALCLs lacking ALK expression are categorized as ALK− ALCL. Therefore, ALK− ALCL is a heterogenous entity. Next-generation sequencing has revealed two recurrent rearrangements in ALK− ALCL: DUSP22 and TP63 rearrangement [21]. The investigation of a large cohort revealed DUSP22 and TP63 rearrangements, respectively, in 30% and 8% of ALK− ALCLs [22]. These two rearrangements are associated with significant clinical features, as described below. Based on these findings, ALCLs are divided into four genetic subtypes: ALK-rearranged, DUSP22-rearranged, TP63-rearranged, and triple-negative ALCL. These rearrangements are mutually exclusive, with the exception of a rare case harboring both DUSP22 and TP63 rearrangements [23].
2.2.2. Clinical Features
ALK− ALCL generally occurs in older adults, with a male-to-female ratio of 3:2. Most patients present with stage III-IV disease and B symptoms [24]. Compared to ALK+ ALCL, ALK− ALCL less frequently exhibits extranodal involvement. Overall, ALK− ALCL has a worse prognosis than ALK+ ALCL but a better prognosis than PTCL-NOS [24]. Notably, DUSP22-reararaged ALCLs have a favorable prognosis, with a 5-year overall survival rate of 90%, which is comparable to that of ALK+ ALCL. In contrast, TP63-rearranged cases have a dismal prognosis, with a 5-year overall survival rate of 17% [22,25].
2.2.3. Morphological and Immunohistochemical Features
Morphologically, ALK− ALCL is similar to the common pattern of ALK+ ALCL, with the presence of hallmark cells, and frequently exhibits a cohesive sheet of large tumor cells with irregular nuclei and sinusoidal involvement. ALK− ALCL is not categorized into different morphological variants [1,8]. Compared to other ALK− ALCLs, DUSP22-rearranged cases are more likely to exhibit a sheet-like growth pattern and doughnut-cell appearance, and they are less likely to display pleomorphism [26].
Immunohistochemically, the tumor cells are strongly and diffusely positive for CD30 on the cell membrane and Golgi region. By definition, ALK is not expressed. Similar to ALK+ ALCL, ALK− ALCL frequently shows the loss of T-cell antigens. However, the majority of ALK− ALCLs express one or more T-cell markers and exhibit some suggestion of a T-cell phenotype. Many cases express cytotoxic markers and EMA but do so less frequently than ALK+ ALCL [24]. DUSP22-rearranged cases show distinct immunohistochemical features; they are generally negative for cytotoxic markers and EMA, while they are generally positive for CD2 and CD3 [22], and they generally express LEF1 [27]. TP63-rearranged cases always show p63 expression, but this is not specific to them [28]. Therefore, p63 cannot be used as a diagnostic marker of TP63- rearranged cases but can be used as a screening tool.
2.2.4. Molecular Features
ALK− ALCLs frequently exhibit JAK-STAT3 pathway activation, which is also a common feature of ALK+ ALCL. Recurrent mutations of JAK1 and STAT3 have been identified in some cases of ALK− ALCL [29]. A subset of cases also show rearrangements of non-ALK tyrosine kinase genes (TYK2, ROS1, and FRK), which result in JAK-STAT3 activation [30]. Notably, DUSP22-rearranged ALCLs exhibit distinct molecular features compared to other ALCLs. They lack STAT3 activation and are characterized by hypomethylation and an immunogenic phenotype that includes the overexpression of immunogenic cancer testis antigen, CD58, and HLA class II and the minimal expression of PD-L1 [29]. A hotspot MSC E116K mutation occurs almost exclusively in DUSP22-rearranged ALCLs [31] (Table 2).

Table 2.
Recurrent genetic alterations and key biomarkers of ALCL.
3. Nodal T-Cell Lymphoma with TFH Cell Origin
According to the WHO classification, nodal T-cell lymphomas with TFH cell origin include three lymphoma types: AITL, nodal PTCL with a TFH phenotype (nPTCL-TFH), and follicular T-cell lymphoma (FTCL) [1]. These lymphomas exhibit a TFH phenotype and are considered a neoplastic counterpart of TFH cells. According to the WHO classification, a TFH lineage of neoplastic cells is indicated by the expression of at least two—and, ideally, three or more—TFH markers.
3.1. AITL
3.1.1. Clinical Features
AITL is a relatively common type of T/NK-cell lymphoma, accounting for 25–30% of such cases [32,33]. AITL most frequently occurs in middle-aged and elderly individuals and presents as a systemic disease. Patients present with generalized lymphadenopathy, and frequently involved extranodal sites include the spleen, liver, skin, and bone marrow. Patients may also exhibit advanced-stage disease, hepatosplenomegaly, and systemic symptoms, such as fever, skin rash, weight loss, and arthritis. Laboratory tests often show immune abnormalities, including polyclonal hypergammaglobulinemia, elevated rheumatoid factor, Coombs-positive hematolytic anemia, positive anti-smooth muscle antibodies, and others [34,35,36]. The prognosis is generally poor, with a median survival of <3 years [33,35,36].
3.1.2. Morphological and Immunohistochemical Features
In AITLs, the lymph nodes are characterized by partial or complete architectural effacement and the marked proliferation of high endothelial venules (HEVs) (Figure 2a). The neoplastic cells of AITLs are typically intermediate-to-medium-sized, with mild nuclear atypia and moderately abundant clear-to-pale cytoplasm (Figure 2b). Tumor cells are accompanied by abundant polymorphous infiltrate, including reactive small lymphocytes, immunoblasts, plasma cells, histiocytes, and eosinophils. The tumor cells may show low cellularity and may be obscured by reactive components. The neoplastic cells tend to form clusters in the vicinity of HEVs. AITLs are often associated with the expansion of extrafollicular follicular dendritic cell (FDC) meshworks, which can be highlighted by immunohistochemistry with CD21 or CD23. These FDC meshworks are most prominent around the HEVs.

Figure 2.
Angioimmunoblastic T-cell lymphoma. (a) Lymph nodes are characterized by partial or complete architectural effacement and a marked proliferation of high endothelial venules (HE × 200). (b) Tumor cells are typically intermediate-to-medium-sized, with mild nuclear atypia and moderately abundant clear-to-pale cytoplasm (HE × 400). (c) Pattern 1 is histologically characterized by many hyperplastic follicles surrounded by atypical lymphocytes (HE × 100). (d) In pattern 2, the follicles are depleted, and regressive follicles remain (HE × 100). (e) In pattern 3, the lymph node architecture is totally or mostly effaced (HE × 100).
Three histological patterns are recognized: patterns 1, 2, and 3 [37]. Pattern 1 is histologically characterized by many hyperplastic follicles surrounded by atypical lymphocytes (Figure 2c). The interfollicular area exhibits HEV proliferation and nuclear cells with a polymorphous inflammatory background. This pattern is difficult to distinguish from reactive follicular hyperplasia. In pattern 2, the follicles are depleted, and regressive follicles remain (Figure 2d). Neoplastic cell expansion is easily recognized in pattern 2 compared to pattern 1. Pattern 3 is the most common pattern and is characterized by a totally or mostly effaced lymph node architecture, with regressed follicles potentially remaining in the periphery of the lymph nodes (Figure 2e).
Immunohistochemically, the neoplastic cells are positive for pan-T-cell markers, such as CD2 and CD3. Most cases are positive for CD4 (Figure 3a) and negative for CD8 (Figure 3b), which is consistent with the TFH origin of AITL. Expressions of pan-T-cell antigens, particularly CD5 or CD7, are frequently downregulated or absent. The tumor cells show positive staining for several TFH markers, including PD-1, ICOS, CXCL13, CD10, and BCL6 (Figure 3c–e). The TFH markers exhibit variable sensitivity and specificity; PD1 and ICOS are more sensitive but less sensitive, while CXCL13 and CD10 are more specific but less sensitive [38,39].

Figure 3.
Immunohistochemistry of angioimmunoblastic T-cell lymphoma. (a,b) Most cases are positive for CD4 (×200) and negative for CD8 (×200). (c–e) Tumor cells show positive staining for several TFH markers (HE × 400). (f) EBV+ B cells are present in the majority of cases (×400).
Immunoblasts in the inflammatory background of AITLs are non-neoplastic B cells and may be positive for EBV (Figure 3f). Previous studies demonstrate that EBV+ B cells are present in 65–95% of AITL cases [35,40,41,42]. The number of EBV+ B cells varies among cases.
3.1.3. Molecular Features
Clonal rearrangements of TCR are found in 75–90% of AITL cases. Additionally, IgH rearrangements are detected in approximately 25–30% of AITL cases. Recent studies show that AITLs have recurrent mutations in genes involved in epigenetic pathways, including TET2 (40–80%), IDH2R172 (30%), and DNMT3A (30%) [43,44,45,46,47]. Other studies have reported hotspot RHOAG17V mutations and mutations in genes involving the TCR signaling pathway, such as PLCG1, CD28, FYN, and VAV1 [44,48,49,50]. Notably, TET2, DNMT3A, and IDH2R172 mutations often co-occur in the same case of AITL. In one study, all AITL cases with RHOAG17V mutations also had TET2 mutation [43]. Furthermore, TET2 and DNMT3A mutations have been identified in the non-tumor cells of patients with AITL and even in the blood cells of healthy individuals [51,52]. On the other hand, the IDH2R172 and RHOAG17V mutations are confined to tumor cells. Based on these findings, a multistep model of tumor development in AITL has been proposed [53].
AITLs with IDH2R172 or RHOAG17V mutations are associated with several morphological and immunohistochemical features. AITL cases with IDH2R172 mutations are characterized by prominent medium-to-large clear cells and a strong expression of TFH markers, particularly CD10 and CXCL13 [54]. AITL cases with RHOAG17V mutations are characterized by a higher density of HEVs, greater FDC expansion, and a more pronounced TFH phenotype compared to wild-type cases [55,56].
3.2. FTCL and nPTCL-TFH
3.2.1. Clinical Features
FTCL is a rare form of PTCL with clinical features similar to those of AITL [57,58]. FTCL occurs in middle-aged and elderly individuals. Patients with FTCL present with generalized lymphadenopathy, splenomegaly, B symptoms, skin rash, and advanced-stage disease. The prognosis appears to be poor. Laboratory tests sometimes reveal immune abnormalities. nPTCL-TFH is not as rare as FTCL. A subset of cases were initially diagnosed as PTCL-NOS and were then identified as having a TFH phenotype.
3.2.2. Morphological and Immunohistochemical Features
In FTCL, the lymph nodes show a nodular/follicular growth pattern (Figure 4a). FTCLs are divided into two histologic patterns: follicular lymphoma-like (FL-like) and the progressive transformation of germinal center-like (PTGC-like) [57,59,60]. In the FL-like pattern, aggregations of intermediate-sized neoplastic cells with round nuclei and pale cytoplasm are observed inside the follicles (Figure 4b), which lack the normal features of follicular B cells. In the PTGC-like pattern, medium-sized neoplastic cells with pale cytoplasm form aggregates surrounded by IgD+ small B cells in an expanded mantle zone. Unlike AITLs, FTCLs lack a polymorphic inflammatory background and HEV proliferation. B immunoblasts are often observed, some of which morphologically and immunohistochemically mimic HRS cells [61]. Immunostaining for CD21 or CD23 can highlight the FDC meshworks in nodular/follicular structures (Figure 4c).
Figure 4.
Follicular T-cell lymphoma. (a) Lymph nodes show a nodular/follicular growth pattern (HE × 40). (b) Aggregations of intermediate-sized neoplastic cells with round nuclei and pale cytoplasm are recognized inside the follicles (HE × 400). (c) Immunostaining with CD21 highlights the FDC meshworks in nodular/follicular structures (HE × 200).
nPTCL-TFH includes cases with a TFH phenotype but without sufficient pathological features to be diagnosed as AITL. Therefore, although some AITL-like features may be recognized, nPTCL-TFH usually exhibits the diffuse proliferation of neoplastic cells without an abundant inflammatory background, HEV proliferation, or FDC expansion.
3.2.3. Molecular Features
The mutational profiles of FTCL and nPTCL-TFH overlap with AITL. Mutations in TET2, DNMT3A, and RHOAG17V are also detected in FTCL and nPTCL-TFH [49,62,63,64]. TET2 mutations seem to be more frequent in FTCL and nPTCL-TFH. IDH2R172 mutations are restricted to FTCLs and AITLs. About 20% of FTCL cases carry a characteristic chromosomal translocation t(5;9)(q33;q22), which results in ITK-SYK fusion [65]. Outside of FTCL, the ITK-SYK fusion has only rarely been detected in AITL (Table 3).

Table 3.
Recurrent genetic alterations and key biomarkers of nodal TFH lymphomas.
3.3. TFH Lymphomas with Hodgkin–Reed–Sternberg (HRS)-Like Cells
Immunoblasts that mimic HRS cells occasionally appear in the background of TFH lymphomas (AITL, nPTCL-TFH, and FTCL) (Figure 5a,b) [61,66,67,68]. Therefore, pathologists may easily misdiagnose THF lymphomas with HRS-like cells as classic Hodgkin lymphoma (cHL). Furthermore, the standard immunostaining used for cHL diagnosis cannot differentiate these HRS-like cells from true HRS cells. We recently revealed that PD-L1 expression is highly frequent in HRS cells (Figure 5c) and rare in HRS-like cells (Figure 5d) [69]. Based on these findings, it was suggested that PD-L1 immunohistochemistry is useful for differentiating these two diseases.

Figure 5.
Follicular helper T-cell (TFH) lymphomas with Hodgkin-Reed-Sternberg (HRS)-like cells. (a,b) The immunoblasts in the background of TFH lymphomas occasionally mimic HRS cells (HE × 400). (c) HRS cells show highly frequent PD-L1 expression (×400). (d) PD-L1 expression is rare in HRS-like cells (×400).
4. ATLL
ATLL is a mature T-cell neoplasm caused by human T-cell leukemia virus type 1 (HTLV-1) retrovirus [1]. Therefore, ATLL frequency is linked to the prevalence of HTLV-1 carriers. ATLL is endemic in several parts of the world, particularly southwest Japan, the Caribbean, Central and South America, and central Africa. Carriers are usually infected by HTLV-1 early in life. ATLL occurs after a long latency, and the cumulative incidence is estimated to be 2–5% among HTLV-1 carriers [70,71,72]. HTLV-1 infection alone is not sufficient for ATLL development, and TAX and HBZ play key roles in ATLL pathogenesis [73]. TAX is a viral oncoprotein that is needed for ATLL initiation and early proliferation, while HBZ is required for neoplasm maintenance. Based on clinical behavior, ATLL is subclassified into four clinical variants: acute, lymphomatous, chronic, and smoldering [74]. Nodal involvement occurs in the acute and lymphomatous variants.
4.1. Clinical Features
Due to the long latency period, ATLL occurs only in adults, with a median onset age of 68 years (ranging from around 30–90 years) [75]. The acute and lymphomatous variants are regarded as aggressive types [74]. Patients with aggressive types of ATLL often exhibit cutaneous lesions, hepatosplenomegaly, and generalized lymphadenopathy. Other frequently involved sites include the central nervous system, gastrointestinal tract, bone, and lung. Laboratory tests reveal elevations of LDH and sIL-2R, hypercalcemia, leukocytosis, and eosinophilia. Due to the associated T-cell immunodeficiency, many patients suffer from frequent opportunistic infections, such as Pneumocystis jirovecii pneumonia, disseminated herpes zoster, and strongyloidiasis. Aggressive ATLLs have a dismal prognosis, with a median survival time of less than one year [76].
The chronic and smoldering variants are regarded as indolent types. Compared to the aggressive variants, they are characterized by a more indolent clinical course and a better prognosis. However, about 25% of indolent ATLLs progress to an acute phase [76,77].
4.2. Morphological and Immunohistochemical Features
The lymph node lesions of ATLLs exhibit a broad spectrum of cytological and morphological features. The lymph nodes are characterized by partial or complete architectural effacement and the diffuse proliferation of neoplastic cells. Tumor cells are usually medium-to-large and pleomorphic (Figure 6a), and small-sized tumor cells with pleomorphic nuclei may also be present. Additionally, anaplastic-like (Figure 6b), multilobed giant cell-like, and blast-like tumor cells are occasionally observed. Rare cases may exhibit AITL-like histological features [78]. Immunohistochemically, neoplastic cells of ATLL express pan-T-cell antigens (CD2, CD3, and CD5) but usually lack CD7 expression (Figure 6c). Most cases are positive for CD4 (Figure 6d) and negative for CD8 (Figure 6e). The majority of ATLLs are positive for CCR4, which is a target of the humanized monoclonal antibody mogamulizumab [79]. About 40% of cases show positive staining for FOXP3, a regulatory T-cell marker [80,81].

Figure 6.
Adult T-cell leukemia/lymphoma. (a) Tumor cells are usually medium-to-large and pleomorphic (HE × 400). (b) Anaplastic-like cells are occasionally present (HE × 400). (c) Tumor cells usually lack CD7 expression (×200). (d,e) Most cases are positive for CD4 (×200) and negative for CD8 (×200).
Other rare morphological variants include Hodgkin-like ATLL [82,83] and ATLL with HTLV-1-infected HRS-like cells (ATLL-HH) [84]. Hodgkin-like ATLL is considered an incipient or early neoplastic phase of ATLL. In Hodgkin-like ATLL, the lymph nodes exhibit small-to-medium-sized lymphocytes with mild nuclear atypia, which diffusely proliferate in expanded paracortical areas (Figure 7a). These atypical lymphocytes are positive for CD3 and CD4 and negative for CD8. Scattered HRS-like cells are observed throughout the paracortical areas (Figure 7a). These HRS-like cells are of the B-cell lineage (Figure 7b), show positive staining for CD30 (Figure 7c) and/or CD15 (Figure 7d), and are frequently infected by EBV (Figure 7e). Notably, HTLV-1 infection is limited to CD4+ T cells, and ultrasensitive RNA in situ hybridization for HBZ shows that HRS-like cells are not infected by HTLV-1 (Figure 7f), implying that HRS-like cells are not neoplastic cells.

Figure 7.
Hodgkin-like adult T-cell leukemia/lymphoma. (a) Small-to-medium-sized lymphocytes with mild nuclear atypia diffusely proliferate with scattered HRS-like cells (HE × 400). (b) The HRS-like cells are of the B-cell lineage (PAX5 × 400). (c–e) The HRS-like cells show positive staining for CD30 (×400) and/or CD15 (×400) and are frequently infected by EBV (×400). (f) HRS-like cells are not infected with HTLV-1 (×400).
ATLL-HH cases are morphologically similar to CHL, exhibiting scattered HRS-like cells intermingled with abundant inflammatory cells (Figure 8a) [84]. In contrast to Hodgkin-like ATLL, the HRS-like cells of ATLL-HH are infected with HTLV-1, as demonstrated by ultrasensitive RNA in situ hybridization for HBZ (Figure 8b). Therefore, these HRS-like cells of ATLL-HH are considered neoplastic cells. Immunohistochemically, these HRS-like cells show positive staining for CD30 (Figure 8c), CD15 (Figure 8d), CD25, and MUM1 and are negative for B-cell markers (Figure 8e), pan-T-cell markers, and EBV. They are frequently positive for CD4 and fascin (Figure 8f).

Figure 8.
Adult T-cell leukemia/lymphoma with HTLV-1-infected HRS-like cells (ATLL-HH). (a) Scattered HRS-like cells are intermingled with abundant inflammatory cells (×400). (b) The HRS-like cells of ATLL-HH are infected by HTLV-1. (c–e) The HRS-like cells show positive staining for CD30 (×400) and CD15 (×400) and are negative for B-cell markers (PAX5 × 400). (f) The HRS-like cells are frequently positive for fascin (×400).
4.3. Molecular and Microenvironmental Features
Recent studies have revealed the hallmark genetic features of ATLL, including genetic alterations involved in the TCR/NF-κβ pathway and the immune escape mechanism. Up to 90% of ATLL cases harbor genomic alterations affecting the TCR/NF-κβ pathway [85,86,87,88]. These include genetic alterations of a proximal component of TCR signaling (e.g., FYN, PLCG1, and VAV1), of the NF-κβ pathway (e.g., PRKCB and CARD11), and of downstream signaling (e.g., IRF4 and RHOA). Around 10% of ATLLs exhibit in-frame fusions related to CD28 (CTLA4-CD28 and ICOS-CD28) [89], which contribute to NF-κβ pathway activation via CD28 costimulatory signaling.
Immune escape mechanisms also play key roles in ATLL pathogenesis. Over half of ATLL cases exhibit alterations in genes associated with immune response modulation. Copy number gains of PD-L1 are frequently detected [85], and the disruption of the 3′-UTR in PD-L1 has been found in 27% of ATLL cases [90]. These alterations of PD-L1 lead to the overexpression of PD-L1 on tumor cells and promote tumor development by inactivating tumor-specific CD8+ T cells via the PD-1/PD-L1 axis. Other genes related to immune response modulation are also altered—including deletions and mutations in HLA-A, HLA-B, and B2M, which are associated with MHC class I, and alterations in CD58 and FAS, which are associated with T-cell and NK-cell immune responses [85,91]. In a large ATLL cohort, immunohistochemical analysis revealed that 7.4% of cases expressed PD-L1 on tumor cells [92]. This neoplastic PD-L1+ group had a poor prognosis compared to the neoplastic PD-L1− group. Within the neoplastic PD-L1− group, the prognosis was better for patients exhibiting microenvironmental PD-L1 expression compared to those lacking microenvironmental PD-L1 expression. In another immunohistochemical study, the prognosis was better among ATLL cases with HLA class II expression on tumor cells than among those without this expression [93]. Furthermore, cases with both neoplastic HLA class II expression on tumor cells and microenvironmental PD-L1 positivity have a significantly better prognosis than the other groups.
CCR4 mutations have been identified in about 30% of ATLL cases [85,94,95]. These mutations result in the up-regulation of CCR4 expression and the activation of the PI3K/AKT pathway. Immunohistochemical analyses show CCR4 expression in 90% of ATLL cases, and CCR4+ patients are likely to have a poorer prognosis than CCR4− patients [79]. ATLL patients with CCR4 expression are good candidates for anti-CCR4 antibody (mogamulizumab) therapy, which shows some effects in ATLL [96].
Clinicogenetic studies of ATLL have highlighted the correlations between genetic alterations and clinical features [97,98]. Mutations of IRF4 and TP53, the amplification of PD-L1, and deletions of CDKN2A are more frequently detected in aggressive variants compared to indolent variants. In aggressive variants, PD-L1 amplifications and PDKCB mutation are independent adverse prognostic factors, according to multivariate analysis. Among indolent variants, IRF4 mutations, PD-L1 amplifications, and CDKN2A deletions are significantly associated with a poor outcome. A recent report highlights the geographical heterogeneity between ATLL cases in North America and Japan [86]. ATLL cases in North America exhibited more frequent mutations related to epigenome and histone modification. In particular, mutations of EP300 were detected in 20% of ATLL cases in North America, compared to 6% in Japanese cohorts (Table 4).

Table 4.
Recurrent genetic alterations and key biomarkers of ATLLs.
5. PTCL-NOS
PTCL-NOS is heterogenous category of nodal and extranodal T-cell lymphomas that do not fulfill the criteria for any specific PTCL entity. The differentiation between nPTCL-TFH and PTCL-NOS requires the immunohistochemical analysis of TFH markers.
5.1. Clinical Features
PTCL-NOS is the most common entity among PTCLs, accounting for approximately 30% of PTCLs. Most cases occur in adults, and children are rarely affected by this disease [1]. The presentation usually includes nodal manifestation, with frequent extranodal involvement. The tumor may primarily occur in extranodal sites, with the most frequently involved sites being the skin and gastrointestinal tract. Most patients present with stage III–IV disease and B symptoms. Eosinophilia, pruritus, or hemophagocytic syndrome may appear as paraneoplastic symptoms. The prognosis of PTCL-NOS is generally poor, with a 5-year OS rate of 20–30% [4,33,99].
5.2. Morphological and Immunohistochemical Features
Since PTCL-NOS is a heterogenous category, the morphological and immunohistochemical features are also heterogenous. Nodal PTCL-NOS usually exhibits diffuse architectural effacement, with some remnants of B cells in the periphery of lymph nodes. Some cases may exhibit an interfollicular or paracortical growth pattern. The cytological spectrum is extremely broad. Pleomorphic medium- and large-sized lymphocytes with irregular nuclei are most frequently observed (Figure 9a). Less common observations include the predominant proliferation of small-sized atypical lymphocytes with irregular nuclei (Figure 9b) or of large cells with immunoblast-like features (Figure 9c). PTCL-NOS is often accompanied by reactive components, including small lymphocytes, histiocytes, eosinophils, B cells, and plasma cells. Scattered EBV-infected B blasts or HRS-like cells may be present.

Figure 9.
Cytological spectrum of peripheral T-cell lymphoma, NOS. (a) Pleomorphic medium- and large-sized type (HE × 400). (b) Pleomorphic small cell type (HE × 400). (c) Large cell immunoblastic type (HE × 400).
Immunohistochemically, the tumor cells are usually positive for pan-T-cell markers (CD2, CD3, CD5, and CD7), although one or several (particularly, CD5 or CD7) may be downregulated or absent. The majority of cases are CD4+/CD8−, while CD4−/CD8+ cases are less frequent, and CD4−/CD8− or CD4/CD8+ cases have also been described.
A lymphoepithelioid variant of PTCL-NOS, also known as Lennert lymphoma, is histologically characterized by numerous clusters of epithelioid histiocytes and the infiltration of small-to-medium-sized lymphocytes with slight nuclear irregularities (Figure 10a). This tumor usually exhibits a cytotoxic phenotype (Figure 10b). Approximately 70–80% of cases are positive for cytotoxic molecules [99,100,101], and 50–80% show CD8 positivity (Figure 10c). This variant exhibits a better prognosis than other PTCL-NOS variants [99,102].

Figure 10.
Lymphoepithelioid variant of peripheral T-cell lymphoma, NOS (Lennert lymphoma). (a) Numerous clusters of epithelioid histiocytes, and the infiltration of small-to-medium-sized lymphocytes with slight nuclear irregularities (HE × 400). (b,c) Tumor cells are usually positive for cytotoxic molecule (TIA-1 × 400) and (CD8 × 400).
Nodal cytotoxic molecule (CM)-positive PTCL-NOS is characterized by the expression of at least one of CM: TIA-1, granzyme B, or perforin. Previous studies have revealed a cytotoxic phenotype in 15–40% of PTCL-NOS cases [100,103,104]. Compared to CM-negative cases, nodal CM-positive PTCL-NOSs are characterized by a younger onset, a poorer performance status, more frequent B symptoms, higher serum LDH, more frequent extranodal involvement, and more frequent EBV positivity. CM-positive cases have a worse prognosis than CM-negative cases [104]. One recent study reported that, among nodal EBV− CM-positive PTCL-NOS cases, the CD5+ cases showed an indolent clinical course [105].
As mentioned above, nodal CM-positive PTCL-NOS includes EBV+ cases. Such cases are now considered a distinct entity: nodal EBV+ cytotoxic T-cell lymphoma (CTL) [106,107,108], which accounts for 21% of PTCL-NOS [104]. Morphologically, these cases all show high-grade morphology, and half exhibit a centroblast-like appearance. Necrosis and an angiocentric pattern are infrequent, in contrast to extranodal NK/T cell lymphoma. Immunohistochemically, they are usually CD8+/CD56−, and the majority are TCRαβ type, although a subset are TCRγδ type or TCR-silent type [107]. In general, nodal EBV+ CTL is characterized by an aggressive clinical course.
5.3. Molecular and Microenvironmental Features
A gene expression study identified two molecular subgroups in PTCL-NOS: the GATA3 subgroup, characterized by the high expression of GATA3 and its target genes (CCR4, IL18RA, CXCR7, and IK); and the TBX21 subgroup, characterized by the high expression of TBX21 and its target genes (CXCR3, IL2RB, CCL3, and IFNγ) [109]. Notably, the GATA3 subgroup exhibited a worse prognosis than the TBX21 subgroup. Within the TBX21 subgroup, cases with a cytotoxic gene signature had poor clinical outcomes. In a subsequent study, genomic copy number analysis and target sequencing revealed that the GATA3 subgroup is characterized by higher genomic complexity and frequent losses or mutations of tumor suppressor genes, such as CDKN2A, TP53, and PTEN [110]. The GATA3 subgroup is also characterized by frequent gains or amplifications of STAT3 and MYC. An immunohistochemistry (IHC) algorithm was generated, in which four antibodies (GATA3, TBX21, CCR4, and CXCR3) are used to identify these two subgroups [111].
A recent comprehensive molecular study identified a subgroup of PTCL-NOS with TP53 and/or CDKN2A mutations and deletions [112]. This subgroup is characterized by a poor prognosis, extensive chromosomal instability, and mutations in genes associated with immune escape and transcriptional regulation (e.g., HLA-A, HLA-B, CD58, and IKZF2). In another study, whole genome sequencing and FISH analysis revealed that the most frequent aberrations among PTCL-NOS cases were CDKN2A deletions (46%) and PTEN deletions (26%) [113]. PTCL-NOS cases with these aberrations are also associated with poor prognosis. This study also demonstrated that the co-occurrence of CDKN2A and PTEN deletions was exclusively detected in PTCL-NOS and that these aberrations were rarely detected in AITL and ALCL. Previous studies of PTCL-NOS have reported recurrent mutations of genes involved in epigenetic regulation, such as TET2 and DNMT3A; however, these studies have included nPTCL-TFH cases. Recent studies that have excluded nPTCL-TFH cases highlight that DNMT3A mutations are rare in PTCL-NOS, while TET2 mutations occur in around 20% of cases [45,112,113]. Similar to other types of T-cell lymphomas, PTCL-NOS can reportedly harbor mutations in genes involved in the TCR signaling pathway—such as PLCG1, CD28, and VAV1—which are associated with aberrations of TP53 and CDKN2A [48,112]. In another recent study, target capture sequencing identified recurrent mutations of FAT1 in 39% of PTCL-NOS cases [114]. FAT1 is a tumor suppressor gene encoding a member of the cadherin superfamily, which binds to β-catenin and inhibits nuclear localization. Patients with FAT1 mutation showed inferior outcomes compared to patients with wild-type FAT1.
In a study focused on microenvironment, the use of the nCounter system revealed a favorable clinical outcome among patients with PTCL-NOS who have both B-cell and dendritic cell (DC) signatures (BD subgroup), compared to an extremely poor prognosis among patients who have neither B-cell nor DC-cell signatures (non-BD subgroup) [115]. Half of the patients in the non-BD subgroup exhibited a macrophage signature (Table 5).

Table 5.
Recurrent genetic alterations and key biomarkers of PTCL-NOSs.
6. Conclusions
Recent pathological and molecular findings in nodal PTCLs have profoundly advanced the identification of tumor signatures and the refinement of the classification. Therefore, the therapies and pathological diagnosis of nodal PTCLs are continually evolving. In this paper, we provide a summary and update of the pathological and molecular features of nodal PTCLs, which will be helpful for diagnostic practice.
Author Contributions
Conceptualization, A.S.; data curation, A.S. and T.T. (Taishi Takahara); writing—original draft preparation, A.S.; writing—review and editing, A.S., T.T. (Taishi Takahara) and T.T. (Toyonori Tsuzuki). All authors have read and agreed to the published version of the manuscript.
Funding
This research was funded by a research grant from the Japan Society for the Promotion of Science (JSPS KAKENHI Grant Number 20K16204).
Conflicts of Interest
The authors declare no conflict of interest.
References
- Swerdlow, S.; Campo, E.; Harris, N.; Jaffe, E.; Pileri, S.; Stein, H.; Thiele, J. (Eds.) WHO Classification of Tumours of Haematopoietic and Lymphoid Tissues, Revised, 4th ed.; International Agency for Research on Cancer: Lyon, France, 2017. [Google Scholar]
- Vega, F.; Amador, C.; Chadburn, A.; Hsi, E.D.; Slack, G.; Medeiros, L.J.; Feldman, A.L. Genetic profiling and biomarkers in peripheral T-cell lymphomas: Current role in the diagnostic work-up. Mod. Pathol. Off. J. USA Can. Acad. Pathol. Inc. 2022, 35, 306–318. [Google Scholar] [CrossRef]
- Chihara, D.; Ito, H.; Matsuda, T.; Shibata, A.; Katsumi, A.; Nakamura, S.; Tomotaka, S.; Morton, L.M.; Weisenburger, D.D.; Matsuo, K. Differences in incidence and trends of haematological malignancies in Japan and the United States. Br. J. Haematol. 2014, 164, 536–545. [Google Scholar] [CrossRef] [PubMed]
- Pileri, S.A.; Tabanelli, V.; Fiori, S.; Calleri, A.; Melle, F.; Motta, G.; Lorenzini, D.; Tarella, C.; Derenzini, E. Peripheral T-Cell Lymphoma, Not Otherwise Specified: Clinical Manifestations, Diagnosis, and Future Treatment. Cancers 2021, 13, 4535. [Google Scholar] [CrossRef]
- Willemze, R.; Jaffe, E.S.; Burg, G.; Cerroni, L.; Berti, E.; Swerdlow, S.H.; Ralfkiaer, E.; Chimenti, S.; Diaz-Perez, J.L.; Duncan, L.M.; et al. WHO-EORTC classification for cutaneous lymphomas. Blood 2005, 105, 3768–3785. [Google Scholar] [CrossRef] [PubMed]
- Bekkenk, M.W.; Geelen, F.A.; van Voorst Vader, P.C.; Heule, F.; Geerts, M.L.; van Vloten, W.A.; Meijer, C.J.; Willemze, R. Primary and secondary cutaneous CD30(+) lymphoproliferative disorders: A report from the Dutch Cutaneous Lymphoma Group on the long-term follow-up data of 219 patients and guidelines for diagnosis and treatment. Blood 2000, 95, 3653–3661. [Google Scholar] [CrossRef]
- Oishi, N.; Miranda, R.N.; Feldman, A.L. Genetics of Breast Implant-Associated Anaplastic Large Cell Lymphoma (BIA-ALCL). Aesthetic Surg. J. 2019, 39, S14–S20. [Google Scholar] [CrossRef]
- Amador, C.; Feldman, A.L. How I Diagnose Anaplastic Large Cell Lymphoma. Am. J. Clin. Pathol. 2021, 155, 479–497. [Google Scholar] [CrossRef]
- Hapgood, G.; Savage, K.J. The biology and management of systemic anaplastic large cell lymphoma. Blood 2015, 126, 17–25. [Google Scholar] [CrossRef] [PubMed]
- Benharroch, D.; Meguerian-Bedoyan, Z.; Lamant, L.; Amin, C.; Brugieres, L.; Terrier-Lacombe, M.J.; Haralambieva, E.; Pulford, K.; Pileri, S.; Morris, S.W.; et al. ALK-positive lymphoma: A single disease with a broad spectrum of morphology. Blood 1998, 91, 2076–2084. [Google Scholar] [CrossRef] [PubMed]
- Lamant, L.; McCarthy, K.; d’Amore, E.; Klapper, W.; Nakagawa, A.; Fraga, M.; Maldyk, J.; Simonitsch-Klupp, I.; Oschlies, I.; Delsol, G.; et al. Prognostic impact of morphologic and phenotypic features of childhood ALK-positive anaplastic large-cell lymphoma: Results of the ALCL99 study. J. Clin. Oncol. Off. J. Am. Soc. Clin. Oncol. 2011, 29, 4669–4676. [Google Scholar] [CrossRef]
- Spiegel, A.; Paillard, C.; Ducassou, S.; Perel, Y.; Plantaz, D.; Strullu, M.; Eischen, A.; Lutz, P.; Lamant, L.; Le Deley, M.C.; et al. Paediatric anaplastic large cell lymphoma with leukaemic presentation in children: A report of nine French cases. Br. J. Haematol. 2014, 165, 545–551. [Google Scholar] [CrossRef]
- Kinney, M.C.; Collins, R.D.; Greer, J.P.; Whitlock, J.A.; Sioutos, N.; Kadin, M.E. A small-cell-predominant variant of primary Ki-1 (CD30)+ T-cell lymphoma. Am. J. Surg. Pathol. 1993, 17, 859–868. [Google Scholar] [CrossRef] [PubMed]
- Satou, A.; Asano, N.; Tatekawa, S.; Fukuyama, R.; Nakamura, S. Lymphohistiocytic and small cell pattern of anaplastic large cell lymphoma, ALK positive, arising in an 86-year-old woman. Pathol. Int. 2013, 63, 230–232. [Google Scholar] [CrossRef] [PubMed]
- Vassallo, J.; Lamant, L.; Brugieres, L.; Gaillard, F.; Campo, E.; Brousset, P.; Delsol, G. ALK-positive anaplastic large cell lymphoma mimicking nodular sclerosis Hodgkin’s lymphoma: Report of 10 cases. Am. J. Surg. Pathol. 2006, 30, 223–229. [Google Scholar] [CrossRef]
- Chan, J.K.; Buchanan, R.; Fletcher, C.D. Sarcomatoid variant of anaplastic large-cell Ki-1 lymphoma. Am. J. Surg. Pathol. 1990, 14, 983–988. [Google Scholar] [CrossRef] [PubMed]
- Jaffe, E.S. Anaplastic large cell lymphoma: The shifting sands of diagnostic hematopathology. Mod. Pathol. Off. J. USA Can. Acad. Pathol. Inc. 2001, 14, 219–228. [Google Scholar] [CrossRef] [PubMed]
- Foss, H.D.; Anagnostopoulos, I.; Araujo, I.; Assaf, C.; Demel, G.; Kummer, J.A.; Hummel, M.; Stein, H. Anaplastic large-cell lymphomas of T-cell and null-cell phenotype express cytotoxic molecules. Blood 1996, 88, 4005–4011. [Google Scholar] [CrossRef] [PubMed]
- de Leval, L. Approach to nodal-based T-cell lymphomas. Pathology 2020, 52, 78–99. [Google Scholar] [CrossRef] [PubMed]
- Boi, M.; Zucca, E.; Inghirami, G.; Bertoni, F. Advances in understanding the pathogenesis of systemic anaplastic large cell lymphomas. Br. J. Haematol. 2015, 168, 771–783. [Google Scholar] [CrossRef]
- Feldman, A.L.; Dogan, A.; Smith, D.I.; Law, M.E.; Ansell, S.M.; Johnson, S.H.; Porcher, J.C.; Ozsan, N.; Wieben, E.D.; Eckloff, B.W.; et al. Discovery of recurrent t(6; 7)(p25.3; q32.3) translocations in ALK-negative anaplastic large cell lymphomas by massively parallel genomic sequencing. Blood 2011, 117, 915–919. [Google Scholar] [CrossRef]
- Parrilla Castellar, E.R.; Jaffe, E.S.; Said, J.W.; Swerdlow, S.H.; Ketterling, R.P.; Knudson, R.A.; Sidhu, J.S.; Hsi, E.D.; Karikehalli, S.; Jiang, L.; et al. ALK-negative anaplastic large cell lymphoma is a genetically heterogeneous disease with widely disparate clinical outcomes. Blood 2014, 124, 1473–1480. [Google Scholar] [CrossRef] [PubMed]
- Karube, K.; Feldman, A.L. “Double-hit” of DUSP22 and TP63 rearrangements in anaplastic large cell lymphoma, ALK-negative. Blood 2020, 135, 700. [Google Scholar] [CrossRef] [PubMed]
- Savage, K.J.; Harris, N.L.; Vose, J.M.; Ullrich, F.; Jaffe, E.S.; Connors, J.M.; Rimsza, L.; Pileri, S.A.; Chhanabhai, M.; Gascoyne, R.D.; et al. ALK- anaplastic large-cell lymphoma is clinically and immunophenotypically different from both ALK+ ALCL and peripheral T-cell lymphoma, not otherwise specified: Report from the International Peripheral T-Cell Lymphoma Project. Blood 2008, 111, 5496–5504. [Google Scholar] [CrossRef] [PubMed]
- Pedersen, M.B.; Hamilton-Dutoit, S.J.; Bendix, K.; Ketterling, R.P.; Bedroske, P.P.; Luoma, I.M.; Sattler, C.A.; Boddicker, R.L.; Bennani, N.N.; Norgaard, P.; et al. DUSP22 and TP63 rearrangements predict outcome of ALK-negative anaplastic large cell lymphoma: A Danish cohort study. Blood 2017, 130, 554–557. [Google Scholar] [CrossRef] [PubMed]
- King, R.L.; Dao, L.N.; McPhail, E.D.; Jaffe, E.S.; Said, J.; Swerdlow, S.H.; Sattler, C.A.; Ketterling, R.P.; Sidhu, J.S.; Hsi, E.D.; et al. Morphologic Features of ALK-negative Anaplastic Large Cell Lymphomas With DUSP22 Rearrangements. Am. J. Surg. Pathol. 2016, 40, 36–43. [Google Scholar] [CrossRef] [PubMed]
- Ravindran, A.; Feldman, A.L.; Ketterling, R.P.; Dasari, S.; Rech, K.L.; McPhail, E.D.; Kurtin, P.J.; Shi, M. Striking Association of Lymphoid Enhancing Factor (LEF1) Overexpression and DUSP22 Rearrangements in Anaplastic Large Cell Lymphoma. Am. J. Surg. Pathol. 2021, 45, 550–557. [Google Scholar] [CrossRef] [PubMed]
- Wang, X.; Boddicker, R.L.; Dasari, S.; Sidhu, J.S.; Kadin, M.E.; Macon, W.R.; Ansell, S.M.; Ketterling, R.P.; Rech, K.L.; Feldman, A.L. Expression of p63 protein in anaplastic large cell lymphoma: Implications for genetic subtyping. Hum. Pathol. 2017, 64, 19–27. [Google Scholar] [CrossRef] [PubMed]
- Luchtel, R.A.; Dasari, S.; Oishi, N.; Pedersen, M.B.; Hu, G.; Rech, K.L.; Ketterling, R.P.; Sidhu, J.; Wang, X.; Katoh, R.; et al. Molecular profiling reveals immunogenic cues in anaplastic large cell lymphomas with DUSP22 rearrangements. Blood 2018, 132, 1386–1398. [Google Scholar] [CrossRef]
- Crescenzo, R.; Abate, F.; Lasorsa, E.; Tabbo, F.; Gaudiano, M.; Chiesa, N.; Di Giacomo, F.; Spaccarotella, E.; Barbarossa, L.; Ercole, E.; et al. Convergent mutations and kinase fusions lead to oncogenic STAT3 activation in anaplastic large cell lymphoma. Cancer Cell 2015, 27, 516–532. [Google Scholar] [CrossRef] [PubMed]
- Luchtel, R.A.; Zimmermann, M.T.; Hu, G.; Dasari, S.; Jiang, M.; Oishi, N.; Jacobs, H.K.; Zeng, Y.; Hundal, T.; Rech, K.L.; et al. Recurrent MSC (E116K) mutations in ALK-negative anaplastic large cell lymphoma. Blood 2019, 133, 2776–2789. [Google Scholar] [CrossRef]
- de Leval, L.; Parrens, M.; Le Bras, F.; Jais, J.P.; Fataccioli, V.; Martin, A.; Lamant, L.; Delarue, R.; Berger, F.; Arbion, F.; et al. Angioimmunoblastic T-cell lymphoma is the most common T-cell lymphoma in two distinct French information data sets. Haematologica 2015, 100, e361–e364. [Google Scholar] [CrossRef] [PubMed]
- Vose, J.; Armitage, J.; Weisenburger, D.; International T-Cell Lymphoma Project. International peripheral T-cell and natural killer/T-cell lymphoma study: Pathology findings and clinical outcomes. J. Clin. Oncol. Off. J. Am. Soc. Clin. Oncol. 2008, 26, 4124–4130. [Google Scholar] [CrossRef]
- Federico, M.; Rudiger, T.; Bellei, M.; Nathwani, B.N.; Luminari, S.; Coiffier, B.; Harris, N.L.; Jaffe, E.S.; Pileri, S.A.; Savage, K.J.; et al. Clinicopathologic characteristics of angioimmunoblastic T-cell lymphoma: Analysis of the international peripheral T-cell lymphoma project. J. Clin. Oncol. Off. J. Am. Soc. Clin. Oncol. 2013, 31, 240–246. [Google Scholar] [CrossRef] [PubMed]
- Tokunaga, T.; Shimada, K.; Yamamoto, K.; Chihara, D.; Ichihashi, T.; Oshima, R.; Tanimoto, M.; Iwasaki, T.; Isoda, A.; Sakai, A.; et al. Retrospective analysis of prognostic factors for angioimmunoblastic T-cell lymphoma: A multicenter cooperative study in Japan. Blood 2012, 119, 2837–2843. [Google Scholar] [CrossRef] [PubMed]
- Mourad, N.; Mounier, N.; Briere, J.; Raffoux, E.; Delmer, A.; Feller, A.; Meijer, C.J.; Emile, J.F.; Bouabdallah, R.; Bosly, A.; et al. Clinical, biologic, and pathologic features in 157 patients with angioimmunoblastic T-cell lymphoma treated within the Groupe d’Etude des Lymphomes de l’Adulte (GELA) trials. Blood 2008, 111, 4463–4470. [Google Scholar] [CrossRef] [PubMed]
- Attygalle, A.D.; Kyriakou, C.; Dupuis, J.; Grogg, K.L.; Diss, T.C.; Wotherspoon, A.C.; Chuang, S.S.; Cabecadas, J.; Isaacson, P.G.; Du, M.Q.; et al. Histologic evolution of angioimmunoblastic T-cell lymphoma in consecutive biopsies: Clinical correlation and insights into natural history and disease progression. Am. J. Surg. Pathol. 2007, 31, 1077–1088. [Google Scholar] [CrossRef] [PubMed]
- Gaulard, P.; de Leval, L. Follicular helper T cells: Implications in neoplastic hematopathology. Semin. Diagn. Pathol. 2011, 28, 202–213. [Google Scholar] [CrossRef] [PubMed]
- Basha, B.M.; Bryant, S.C.; Rech, K.L.; Feldman, A.L.; Vrana, J.A.; Shi, M.; Reed, K.A.; King, R.L. Application of a 5 Marker Panel to the Routine Diagnosis of Peripheral T-Cell Lymphoma with T-Follicular Helper Phenotype. Am. J. Surg. Pathol. 2019, 43, 1282–1290. [Google Scholar] [CrossRef]
- Eladl, A.E.; Shimada, K.; Suzuki, Y.; Takahara, T.; Kato, S.; Kohno, K.; Elsayed, A.A.; Wu, C.C.; Tokunaga, T.; Kinoshita, T.; et al. EBV status has prognostic implication among young patients with angioimmunoblastic T-cell lymphoma. Cancer Med. 2020, 9, 678–688. [Google Scholar] [CrossRef]
- Zettl, A.; Lee, S.S.; Rudiger, T.; Starostik, P.; Marino, M.; Kirchner, T.; Ott, M.; Muller-Hermelink, H.K.; Ott, G. Epstein-Barr virus-associated B-cell lymphoproliferative disorders in angloimmunoblastic T-cell lymphoma and peripheral T-cell lymphoma, unspecified. Am. J. Clin. Pathol. 2002, 117, 368–379. [Google Scholar] [CrossRef]
- Weiss, L.M.; Jaffe, E.S.; Liu, X.F.; Chen, Y.Y.; Shibata, D.; Medeiros, L.J. Detection and localization of Epstein-Barr viral genomes in angioimmunoblastic lymphadenopathy and angioimmunoblastic lymphadenopathy-like lymphoma. Blood 1992, 79, 1789–1795. [Google Scholar] [CrossRef]
- Sakata-Yanagimoto, M.; Enami, T.; Yoshida, K.; Shiraishi, Y.; Ishii, R.; Miyake, Y.; Muto, H.; Tsuyama, N.; Sato-Otsubo, A.; Okuno, Y.; et al. Somatic RHOA mutation in angioimmunoblastic T cell lymphoma. Nat. Genet. 2014, 46, 171–175. [Google Scholar] [CrossRef]
- Palomero, T.; Couronne, L.; Khiabanian, H.; Kim, M.Y.; Ambesi-Impiombato, A.; Perez-Garcia, A.; Carpenter, Z.; Abate, F.; Allegretta, M.; Haydu, J.E.; et al. Recurrent mutations in epigenetic regulators, RHOA and FYN kinase in peripheral T cell lymphomas. Nat. Genet. 2014, 46, 166–170. [Google Scholar] [CrossRef] [PubMed]
- Lemonnier, F.; Couronne, L.; Parrens, M.; Jais, J.P.; Travert, M.; Lamant, L.; Tournillac, O.; Rousset, T.; Fabiani, B.; Cairns, R.A.; et al. Recurrent TET2 mutations in peripheral T-cell lymphomas correlate with TFH-like features and adverse clinical parameters. Blood 2012, 120, 1466–1469. [Google Scholar] [CrossRef] [PubMed]
- Cairns, R.A.; Iqbal, J.; Lemonnier, F.; Kucuk, C.; de Leval, L.; Jais, J.P.; Parrens, M.; Martin, A.; Xerri, L.; Brousset, P.; et al. IDH2 mutations are frequent in angioimmunoblastic T-cell lymphoma. Blood 2012, 119, 1901–1903. [Google Scholar] [CrossRef] [PubMed]
- Lemonnier, F.; Cairns, R.A.; Inoue, S.; Li, W.Y.; Dupuy, A.; Broutin, S.; Martin, N.; Fataccioli, V.; Pelletier, R.; Wakeham, A.; et al. The IDH2 R172K mutation associated with angioimmunoblastic T-cell lymphoma produces 2HG in T cells and impacts lymphoid development. Proc. Natl. Acad. Sci. USA 2016, 113, 15084–15089. [Google Scholar] [CrossRef] [PubMed]
- Rohr, J.; Guo, S.; Huo, J.; Bouska, A.; Lachel, C.; Li, Y.; Simone, P.D.; Zhang, W.; Gong, Q.; Wang, C.; et al. Recurrent activating mutations of CD28 in peripheral T-cell lymphomas. Leukemia 2016, 30, 1062–1070. [Google Scholar] [CrossRef]
- Vallois, D.; Dobay, M.P.; Morin, R.D.; Lemonnier, F.; Missiaglia, E.; Juilland, M.; Iwaszkiewicz, J.; Fataccioli, V.; Bisig, B.; Roberti, A.; et al. Activating mutations in genes related to TCR signaling in angioimmunoblastic and other follicular helper T-cell-derived lymphomas. Blood 2016, 128, 1490–1502. [Google Scholar] [CrossRef]
- Fujisawa, M.; Sakata-Yanagimoto, M.; Nishizawa, S.; Komori, D.; Gershon, P.; Kiryu, M.; Tanzima, S.; Fukumoto, K.; Enami, T.; Muratani, M.; et al. Activation of RHOA-VAV1 signaling in angioimmunoblastic T-cell lymphoma. Leukemia 2018, 32, 694–702. [Google Scholar] [CrossRef]
- Genovese, G.; Kahler, A.K.; Handsaker, R.E.; Lindberg, J.; Rose, S.A.; Bakhoum, S.F.; Chambert, K.; Mick, E.; Neale, B.M.; Fromer, M.; et al. Clonal hematopoiesis and blood-cancer risk inferred from blood DNA sequence. N. Engl. J. Med. 2014, 371, 2477–2487. [Google Scholar] [CrossRef] [PubMed]
- Jaiswal, S.; Fontanillas, P.; Flannick, J.; Manning, A.; Grauman, P.V.; Mar, B.G.; Lindsley, R.C.; Mermel, C.H.; Burtt, N.; Chavez, A.; et al. Age-related clonal hematopoiesis associated with adverse outcomes. N. Engl. J. Med. 2014, 371, 2488–2498. [Google Scholar] [CrossRef] [PubMed]
- Sakata-Yanagimoto, M. Multistep tumorigenesis in peripheral T cell lymphoma. Int. J. Hematol. 2015, 102, 523–527. [Google Scholar] [CrossRef]
- Steinhilber, J.; Mederake, M.; Bonzheim, I.; Serinsoz-Linke, E.; Muller, I.; Fallier-Becker, P.; Lemonnier, F.; Gaulard, P.; Fend, F.; Quintanilla-Martinez, L. The pathological features of angioimmunoblastic T-cell lymphomas with IDH2(R172) mutations. Mod. Pathol. Off. J. USA Can. Acad. Pathol. Inc. 2019, 32, 1123–1134. [Google Scholar] [CrossRef]
- Nagao, R.; Kikuti, Y.Y.; Carreras, J.; Kikuchi, T.; Miyaoka, M.; Matsushita, H.; Kojima, M.; Ando, K.; Sakata-Yanagimoto, M.; Chiba, S.; et al. Clinicopathologic Analysis of Angioimmunoblastic T-cell Lymphoma with or without RHOA G17V Mutation Using Formalin-fixed Paraffin-embedded Sections. Am. J. Surg. Pathol. 2016, 40, 1041–1050. [Google Scholar] [CrossRef] [PubMed]
- Ondrejka, S.L.; Grzywacz, B.; Bodo, J.; Makishima, H.; Polprasert, C.; Said, J.W.; Przychodzen, B.; Maciejewski, J.P.; Hsi, E.D. Angioimmunoblastic T-cell Lymphomas with the RHOA p.Gly17Val Mutation Have Classic Clinical and Pathologic Features. Am. J. Surg. Pathol. 2016, 40, 335–341. [Google Scholar] [CrossRef] [PubMed]
- Huang, Y.; Moreau, A.; Dupuis, J.; Streubel, B.; Petit, B.; Le Gouill, S.; Martin-Garcia, N.; Copie-Bergman, C.; Gaillard, F.; Qubaja, M.; et al. Peripheral T-cell lymphomas with a follicular growth pattern are derived from follicular helper T cells (TFH) and may show overlapping features with angioimmunoblastic T-cell lymphomas. Am. J. Surg. Pathol. 2009, 33, 682–690. [Google Scholar] [CrossRef]
- Miyoshi, H.; Sato, K.; Niino, D.; Arakawa, F.; Kimura, Y.; Kiyasu, J.; Takeuchi, M.; Yoshida, M.; Okada, Y.; Nakamura, Y.; et al. Clinicopathologic analysis of peripheral T-cell lymphoma, follicular variant, and comparison with angioimmunoblastic T-cell lymphoma: Bcl-6 expression might affect progression between these disorders. Am. J. Clin. Pathol. 2012, 137, 879–889. [Google Scholar] [CrossRef] [PubMed]
- de Leval, L.; Savilo, E.; Longtine, J.; Ferry, J.A.; Harris, N.L. Peripheral T-cell lymphoma with follicular involvement and a CD4+/bcl-6+ phenotype. Am. J. Surg. Pathol. 2001, 25, 395–400. [Google Scholar] [CrossRef]
- Ikonomou, I.M.; Tierens, A.; Troen, G.; Aamot, H.V.; Heim, S.; Lauritzsen, G.F.; Valerhaugen, H.; Delabie, J. Peripheral T-cell lymphoma with involvement of the expanded mantle zone. Virchows Arch. Int. J. Pathol. 2006, 449, 78–87. [Google Scholar] [CrossRef] [PubMed]
- Alikhan, M.; Song, J.Y.; Sohani, A.R.; Moroch, J.; Plonquet, A.; Duffield, A.S.; Borowitz, M.J.; Jiang, L.; Bueso-Ramos, C.; Inamdar, K.; et al. Peripheral T-cell lymphomas of follicular helper T-cell type frequently display an aberrant CD3(-/dim)CD4(+) population by flow cytometry: An important clue to the diagnosis of a Hodgkin lymphoma mimic. Mod. Pathol. Off. J. USA Can. Acad. Pathol. Inc. 2016, 29, 1173–1182. [Google Scholar] [CrossRef]
- Dobay, M.P.; Lemonnier, F.; Missiaglia, E.; Bastard, C.; Vallois, D.; Jais, J.P.; Scourzic, L.; Dupuy, A.; Fataccioli, V.; Pujals, A.; et al. Integrative clinicopathological and molecular analyses of angioimmunoblastic T-cell lymphoma and other nodal lymphomas of follicular helper T-cell origin. Haematologica 2017, 102, e148–e151. [Google Scholar] [CrossRef]
- Debackere, K.; van der Krogt, J.A.; Tousseyn, T.; Ferreiro, J.A.F.; Van Roosbroeck, K.; Marcelis, L.; Graux, C.; Dierickx, D.; Ameye, G.; Vandenberghe, P.; et al. FER and FES tyrosine kinase fusions in follicular T-cell lymphoma. Blood 2020, 135, 584–588. [Google Scholar] [CrossRef] [PubMed]
- Miyoshi, H.; Sakata-Yanagimoto, M.; Shimono, J.; Yoshida, N.; Hattori, K.; Arakawa, F.; Yanagida, E.; Takeuchi, M.; Yamada, K.; Suzuki, T.; et al. RHOA mutation in follicular T-cell lymphoma: Clinicopathological analysis of 16 cases. Pathol. Int. 2020, 70, 653–660. [Google Scholar] [CrossRef] [PubMed]
- Streubel, B.; Vinatzer, U.; Willheim, M.; Raderer, M.; Chott, A. Novel t(5; 9)(q33; q22) fuses ITK to SYK in unspecified peripheral T-cell lymphoma. Leukemia 2006, 20, 313–318. [Google Scholar] [CrossRef] [PubMed]
- Eladl, A.E.; Satou, A.; Elsayed, A.A.; Suzuki, Y.; Kato, S.; Asano, N.; Nakamura, S. Clinicopathological Study of 30 Cases of Peripheral T-cell Lymphoma with Hodgkin and Reed-Sternberg-like B-cells from Japan. Am. J. Surg. Pathol. 2017, 41, 506–516. [Google Scholar] [CrossRef]
- Nicolae, A.; Pittaluga, S.; Venkataraman, G.; Vijnovich-Baron, A.; Xi, L.; Raffeld, M.; Jaffe, E.S. Peripheral T-cell lymphomas of follicular T-helper cell derivation with Hodgkin/Reed-Sternberg cells of B-cell lineage: Both EBV-positive and EBV-negative variants exist. Am. J. Surg. Pathol. 2013, 37, 816–826. [Google Scholar] [CrossRef] [PubMed]
- Quintanilla-Martinez, L.; Fend, F.; Moguel, L.R.; Spilove, L.; Beaty, M.W.; Kingma, D.W.; Raffeld, M.; Jaffe, E.S. Peripheral T-cell lymphoma with Reed-Sternberg-like cells of B-cell phenotype and genotype associated with Epstein-Barr virus infection. Am. J. Surg. Pathol. 1999, 23, 1233–1240. [Google Scholar] [CrossRef]
- Sakakibara, A.; Kohno, K.; Eladl, A.E.; Klaisuwan, T.; Ishikawa, E.; Suzuki, Y.; Shimada, S.; Nakaguro, M.; Shimoyama, Y.; Takahara, T.; et al. Immunohistochemical assessment of the diagnostic utility of PD-L1: A preliminary analysis of anti-PD-L1 antibody (SP142) for lymphoproliferative diseases with tumour and non-malignant Hodgkin-Reed-Sternberg (HRS)-like cells. Histopathology 2018, 72, 1156–1163. [Google Scholar] [CrossRef] [PubMed]
- Arisawa, K.; Soda, M.; Endo, S.; Kurokawa, K.; Katamine, S.; Shimokawa, I.; Koba, T.; Takahashi, T.; Saito, H.; Doi, H.; et al. Evaluation of adult T-cell leukemia/lymphoma incidence and its impact on non-Hodgkin lymphoma incidence in southwestern Japan. Int. J. Cancer 2000, 85, 319–324. [Google Scholar] [CrossRef]
- Tajima, K. The 4th nation-wide study of adult T-cell leukemia/lymphoma (ATL) in Japan: Estimates of risk of ATL and its geographical and clinical features. The T- and B-cell Malignancy Study Group. Int. J. Cancer 1990, 45, 237–243. [Google Scholar] [CrossRef]
- Tokudome, S.; Tokunaga, O.; Shimamoto, Y.; Miyamoto, Y.; Sumida, I.; Kikuchi, M.; Takeshita, M.; Ikeda, T.; Fujiwara, K.; Yoshihara, M.; et al. Incidence of adult T-cell leukemia/lymphoma among human T-lymphotropic virus type I carriers in Saga, Japan. Cancer Res. 1989, 49, 226–228. [Google Scholar] [PubMed]
- Matsuoka, M.; Jeang, K.T. Human T-cell leukaemia virus type 1 (HTLV-1) infectivity and cellular transformation. Nat. Rev. Cancer 2007, 7, 270–280. [Google Scholar] [CrossRef] [PubMed]
- Shimoyama, M. Diagnostic criteria and classification of clinical subtypes of adult T-cell leukaemia-lymphoma. A report from the Lymphoma Study Group (1984-87). Br. J. Haematol. 1991, 79, 428–437. [Google Scholar] [CrossRef]
- Ito, S.; Iwanaga, M.; Nosaka, K.; Imaizumi, Y.; Ishitsuka, K.; Amano, M.; Utsunomiya, A.; Tokura, Y.; Watanabe, T.; Uchimaru, K.; et al. Epidemiology of adult T-cell leukemia-lymphoma in Japan: An updated analysis, 2012–2013. Cancer Sci. 2021, 112, 4346–4354. [Google Scholar] [CrossRef] [PubMed]
- Katsuya, H.; Ishitsuka, K.; Utsunomiya, A.; Hanada, S.; Eto, T.; Moriuchi, Y.; Saburi, Y.; Miyahara, M.; Sueoka, E.; Uike, N.; et al. Treatment and survival among 1594 patients with ATL. Blood 2015, 126, 2570–2577. [Google Scholar] [CrossRef] [PubMed]
- Tsukasaki, K.; Hermine, O.; Bazarbachi, A.; Ratner, L.; Ramos, J.C.; Harrington, W., Jr.; O’Mahony, D.; Janik, J.E.; Bittencourt, A.L.; Taylor, G.P.; et al. Definition, prognostic factors, treatment, and response criteria of adult T-cell leukemia-lymphoma: A proposal from an international consensus meeting. J. Clin. Oncol. Off. J. Am. Soc. Clin. Oncol. 2009, 27, 453–459. [Google Scholar] [CrossRef]
- Karube, K.; Suzumiya, J.; Okamoto, M.; Takeshita, M.; Maeda, K.; Sakaguchi, M.; Inada, T.; Tsushima, H.; Kikuchi, M.; Ohshima, K. Adult T-cell lymphoma/leukemia with angioimmunoblastic T-cell lymphomalike features: Report of 11 cases. Am. J. Surg. Pathol. 2007, 31, 216–223. [Google Scholar] [CrossRef]
- Ishida, T.; Utsunomiya, A.; Iida, S.; Inagaki, H.; Takatsuka, Y.; Kusumoto, S.; Takeuchi, G.; Shimizu, S.; Ito, M.; Komatsu, H.; et al. Clinical significance of CCR4 expression in adult T-cell leukemia/lymphoma: Its close association with skin involvement and unfavorable outcome. Clin. Cancer Res. Off. J. Am. Assoc. Cancer Res. 2003, 9, 3625–3634. [Google Scholar]
- Karube, K.; Ohshima, K.; Tsuchiya, T.; Yamaguchi, T.; Kawano, R.; Suzumiya, J.; Utsunomiya, A.; Harada, M.; Kikuchi, M. Expression of FoxP3, a key molecule in CD4CD25 regulatory T cells, in adult T-cell leukaemia/lymphoma cells. Br. J. Haematol. 2004, 126, 81–84. [Google Scholar] [CrossRef] [PubMed]
- Karube, K.; Aoki, R.; Sugita, Y.; Yoshida, S.; Nomura, Y.; Shimizu, K.; Kimura, Y.; Hashikawa, K.; Takeshita, M.; Suzumiya, J.; et al. The relationship of FOXP3 expression and clinicopathological characteristics in adult T-cell leukemia/lymphoma. Mod. Pathol. Off. J. USA Can. Acad. Pathol. Inc. 2008, 21, 617–625. [Google Scholar] [CrossRef] [PubMed]
- Ohshima, K.; Suzumiya, J.; Kato, A.; Tashiro, K.; Kikuchi, M. Clonal HTLV-I-infected CD4+ T-lymphocytes and non-clonal non-HTLV-I-infected giant cells in incipient ATLL with Hodgkin-like histologic features. Int. J. Cancer 1997, 72, 592–598. [Google Scholar] [CrossRef]
- Venkataraman, G.; Berkowitz, J.; Morris, J.C.; Janik, J.E.; Raffeld, M.A.; Pittaluga, S. Adult T-cell leukemia/lymphoma with Epstein-Barr virus-positive Hodgkin-like cells. Hum. Pathol. 2011, 42, 1042–1046. [Google Scholar] [CrossRef] [PubMed]
- Karube, K.; Takatori, M.; Sakihama, S.; Tsuruta, Y.; Miyagi, T.; Morichika, K.; Kitamura, S.; Nakada, N.; Hayashi, M.; Tomori, S.; et al. Clinicopathological features of adult T-cell leukemia/lymphoma with HTLV-1-infected Hodgkin and Reed-Sternberg-like cells. Blood Adv. 2021, 5, 198–206. [Google Scholar] [CrossRef] [PubMed]
- Kataoka, K.; Nagata, Y.; Kitanaka, A.; Shiraishi, Y.; Shimamura, T.; Yasunaga, J.; Totoki, Y.; Chiba, K.; Sato-Otsubo, A.; Nagae, G.; et al. Integrated molecular analysis of adult T cell leukemia/lymphoma. Nat. Genet. 2015, 47, 1304–1315. [Google Scholar] [CrossRef] [PubMed]
- Shah, U.A.; Chung, E.Y.; Giricz, O.; Pradhan, K.; Kataoka, K.; Gordon-Mitchell, S.; Bhagat, T.D.; Mai, Y.; Wei, Y.; Ishida, E.; et al. North American ATLL has a distinct mutational and transcriptional profile and responds to epigenetic therapies. Blood 2018, 132, 1507–1518. [Google Scholar] [CrossRef]
- Kogure, Y.; Kataoka, K. Genetic alterations in adult T-cell leukemia/lymphoma. Cancer Sci. 2017, 108, 1719–1725. [Google Scholar] [CrossRef] [PubMed]
- Yoshida, N.; Miyoshi, H.; Ohshima, K. Clinical Applications of Genomic Alterations in ATLL: Predictive Markers and Therapeutic Targets. Cancers 2021, 13, 1801. [Google Scholar] [CrossRef]
- Yoshida, N.; Shigemori, K.; Donaldson, N.; Trevisani, C.; Cordero, N.A.; Stevenson, K.E.; Bu, X.; Arakawa, F.; Takeuchi, M.; Ohshima, K.; et al. Genomic landscape of young ATLL patients identifies frequent targetable CD28 fusions. Blood 2020, 135, 1467–1471. [Google Scholar] [CrossRef]
- Kataoka, K.; Shiraishi, Y.; Takeda, Y.; Sakata, S.; Matsumoto, M.; Nagano, S.; Maeda, T.; Nagata, Y.; Kitanaka, A.; Mizuno, S.; et al. Aberrant PD-L1 expression through 3’-UTR disruption in multiple cancers. Nature 2016, 534, 402–406. [Google Scholar] [CrossRef] [PubMed]
- Yoshida, N.; Karube, K.; Utsunomiya, A.; Tsukasaki, K.; Imaizumi, Y.; Taira, N.; Uike, N.; Umino, A.; Arita, K.; Suguro, M.; et al. Molecular characterization of chronic-type adult T-cell leukemia/lymphoma. Cancer Res. 2014, 74, 6129–6138. [Google Scholar] [CrossRef] [PubMed]
- Miyoshi, H.; Kiyasu, J.; Kato, T.; Yoshida, N.; Shimono, J.; Yokoyama, S.; Taniguchi, H.; Sasaki, Y.; Kurita, D.; Kawamoto, K.; et al. PD-L1 expression on neoplastic or stromal cells is respectively a poor or good prognostic factor for adult T-cell leukemia/lymphoma. Blood 2016, 128, 1374–1381. [Google Scholar] [CrossRef]
- Takeuchi, M.; Miyoshi, H.; Asano, N.; Yoshida, N.; Yamada, K.; Yanagida, E.; Moritsubo, M.; Nakata, M.; Umeno, T.; Suzuki, T.; et al. Human leukocyte antigen class II expression is a good prognostic factor in adult T-cell leukemia/lymphoma. Haematologica 2019, 104, 1626–1632. [Google Scholar] [CrossRef] [PubMed]
- Yoshida, N.; Miyoshi, H.; Kato, T.; Sakata-Yanagimoto, M.; Niino, D.; Taniguchi, H.; Moriuchi, Y.; Miyahara, M.; Kurita, D.; Sasaki, Y.; et al. CCR4 frameshift mutation identifies a distinct group of adult T cell leukaemia/lymphoma with poor prognosis. J. Pathol. 2016, 238, 621–626. [Google Scholar] [CrossRef]
- Nakagawa, M.; Schmitz, R.; Xiao, W.; Goldman, C.K.; Xu, W.; Yang, Y.; Yu, X.; Waldmann, T.A.; Staudt, L.M. Gain-of-function CCR4 mutations in adult T cell leukemia/lymphoma. J. Exp. Med. 2014, 211, 2497–2505. [Google Scholar] [CrossRef]
- Sakamoto, Y.; Ishida, T.; Masaki, A.; Murase, T.; Yonekura, K.; Tashiro, Y.; Tokunaga, M.; Utsunomiya, A.; Ito, A.; Kusumoto, S.; et al. CCR4 mutations associated with superior outcome of adult T-cell leukemia/lymphoma under mogamulizumab treatment. Blood 2018, 132, 758–761. [Google Scholar] [CrossRef] [PubMed]
- Kataoka, K.; Iwanaga, M.; Yasunaga, J.I.; Nagata, Y.; Kitanaka, A.; Kameda, T.; Yoshimitsu, M.; Shiraishi, Y.; Sato-Otsubo, A.; Sanada, M.; et al. Prognostic relevance of integrated genetic profiling in adult T-cell leukemia/lymphoma. Blood 2018, 131, 215–225. [Google Scholar] [CrossRef]
- Yoshida, N.; Weinstock, D.M. Clinicogenetic risk modeling in ATL. Blood 2018, 131, 159–160. [Google Scholar] [CrossRef] [PubMed]
- Weisenburger, D.D.; Savage, K.J.; Harris, N.L.; Gascoyne, R.D.; Jaffe, E.S.; MacLennan, K.A.; Rudiger, T.; Pileri, S.; Nakamura, S.; Nathwani, B.; et al. Peripheral T-cell lymphoma, not otherwise specified: A report of 340 cases from the International Peripheral T-cell Lymphoma Project. Blood 2011, 117, 3402–3408. [Google Scholar] [CrossRef] [PubMed]
- Geissinger, E.; Odenwald, T.; Lee, S.S.; Bonzheim, I.; Roth, S.; Reimer, P.; Wilhelm, M.; Muller-Hermelink, H.K.; Rudiger, T. Nodal peripheral T-cell lymphomas and, in particular, their lymphoepithelioid (Lennert’s) variant are often derived from CD8(+) cytotoxic T-cells. Virchows Arch. Int. J. Pathol. 2004, 445, 334–343. [Google Scholar] [CrossRef]
- Yamashita, Y.; Nakamura, S.; Kagami, Y.; Hasegawa, Y.; Kojima, H.; Nagasawa, T.; Mori, N. Lennert’s lymphoma: A variant of cytotoxic T-cell lymphoma? Am. J. Surg. Pathol. 2000, 24, 1627–1633. [Google Scholar] [CrossRef]
- Spier, C.M.; Lippman, S.M.; Miller, T.P.; Grogan, T.M. Lennert’s lymphoma. A clinicopathologic study with emphasis on phenotype and its relationship to survival. Cancer 1988, 61, 517–524. [Google Scholar] [CrossRef]
- Went, P.; Agostinelli, C.; Gallamini, A.; Piccaluga, P.P.; Ascani, S.; Sabattini, E.; Bacci, F.; Falini, B.; Motta, T.; Paulli, M.; et al. Marker expression in peripheral T-cell lymphoma: A proposed clinical-pathologic prognostic score. J. Clin. Oncol. Off. J. Am. Soc. Clin. Oncol. 2006, 24, 2472–2479. [Google Scholar] [CrossRef] [PubMed]
- Asano, N.; Suzuki, R.; Kagami, Y.; Ishida, F.; Kitamura, K.; Fukutani, H.; Morishima, Y.; Takeuchi, K.; Nakamura, S. Clinicopathologic and prognostic significance of cytotoxic molecule expression in nodal peripheral T-cell lymphoma, unspecified. Am. J. Surg. Pathol. 2005, 29, 1284–1293. [Google Scholar] [CrossRef]
- Yamashita, D.; Shimada, K.; Takata, K.; Miyata-Takata, T.; Kohno, K.; Satou, A.; Sakakibara, A.; Nakamura, S.; Asano, N.; Kato, S. Reappraisal of nodal Epstein-Barr Virus-negative cytotoxic T-cell lymphoma: Identification of indolent CD5(+) diseases. Cancer Sci. 2018, 109, 2599–2610. [Google Scholar] [CrossRef] [PubMed]
- Kato, S.; Takahashi, E.; Asano, N.; Tanaka, T.; Megahed, N.; Kinoshita, T.; Nakamura, S. Nodal cytotoxic molecule (CM)-positive Epstein-Barr virus (EBV)-associated peripheral T cell lymphoma (PTCL): A clinicopathological study of 26 cases. Histopathology 2012, 61, 186–199. [Google Scholar] [CrossRef] [PubMed]
- Kato, S.; Asano, N.; Miyata-Takata, T.; Takata, K.; Elsayed, A.A.; Satou, A.; Takahashi, E.; Kinoshita, T.; Nakamura, S. T-cell receptor (TCR) phenotype of nodal Epstein-Barr virus (EBV)-positive cytotoxic T-cell lymphoma (CTL): A clinicopathologic study of 39 cases. Am. J. Surg. Pathol. 2015, 39, 462–471. [Google Scholar] [CrossRef]
- Kato, S.; Yamashita, D.; Nakamura, S. Nodal EBV+ cytotoxic T-cell lymphoma: A literature review based on the 2017 WHO classification. J. Clin. Exp. Hematop. 2020, 60, 30–36. [Google Scholar] [CrossRef]
- Iqbal, J.; Wright, G.; Wang, C.; Rosenwald, A.; Gascoyne, R.D.; Weisenburger, D.D.; Greiner, T.C.; Smith, L.; Guo, S.; Wilcox, R.A.; et al. Gene expression signatures delineate biological and prognostic subgroups in peripheral T-cell lymphoma. Blood 2014, 123, 2915–2923. [Google Scholar] [CrossRef]
- Heavican, T.B.; Bouska, A.; Yu, J.; Lone, W.; Amador, C.; Gong, Q.; Zhang, W.; Li, Y.; Dave, B.J.; Nairismagi, M.L.; et al. Genetic drivers of oncogenic pathways in molecular subgroups of peripheral T-cell lymphoma. Blood 2019, 133, 1664–1676. [Google Scholar] [CrossRef]
- Amador, C.; Greiner, T.C.; Heavican, T.B.; Smith, L.M.; Galvis, K.T.; Lone, W.; Bouska, A.; D’Amore, F.; Pedersen, M.B.; Pileri, S.; et al. Reproducing the molecular subclassification of peripheral T-cell lymphoma-NOS by immunohistochemistry. Blood 2019, 134, 2159–2170. [Google Scholar] [CrossRef]
- Watatani, Y.; Sato, Y.; Miyoshi, H.; Sakamoto, K.; Nishida, K.; Gion, Y.; Nagata, Y.; Shiraishi, Y.; Chiba, K.; Tanaka, H.; et al. Molecular heterogeneity in peripheral T-cell lymphoma, not otherwise specified revealed by comprehensive genetic profiling. Leukemia 2019, 33, 2867–2883. [Google Scholar] [CrossRef] [PubMed]
- Maura, F.; Dodero, A.; Carniti, C.; Bolli, N.; Magni, M.; Monti, V.; Cabras, A.; Leongamornlert, D.; Abascal, F.; Diamond, B.; et al. CDKN2A deletion is a frequent event associated with poor outcome in patients with peripheral T-cell lymphoma not otherwise specified (PTCL-NOS). Haematologica 2021, 106, 2918–2926. [Google Scholar] [CrossRef] [PubMed]
- Laginestra, M.A.; Cascione, L.; Motta, G.; Fuligni, F.; Agostinelli, C.; Rossi, M.; Sapienza, M.R.; Righi, S.; Broccoli, A.; Indio, V.; et al. Whole exome sequencing reveals mutations in FAT1 tumor suppressor gene clinically impacting on peripheral T-cell lymphoma not otherwise specified. Mod. Pathol. Off. J. USA Can. Acad. Pathol. Inc. 2020, 33, 179–187. [Google Scholar] [CrossRef] [PubMed]
- Sugio, T.; Miyawaki, K.; Kato, K.; Sasaki, K.; Yamada, K.; Iqbal, J.; Miyamoto, T.; Ohshima, K.; Maeda, T.; Miyoshi, H.; et al. Microenvironmental immune cell signatures dictate clinical outcomes for PTCL-NOS. Blood Adv. 2018, 2, 2242–2252. [Google Scholar] [CrossRef] [PubMed]
Publisher’s Note: MDPI stays neutral with regard to jurisdictional claims in published maps and institutional affiliations. |
© 2022 by the authors. Licensee MDPI, Basel, Switzerland. This article is an open access article distributed under the terms and conditions of the Creative Commons Attribution (CC BY) license (https://creativecommons.org/licenses/by/4.0/).